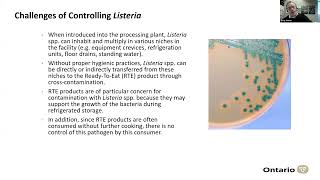
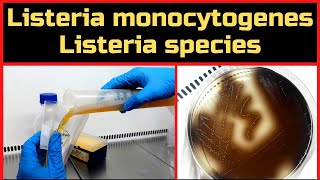

Unknown
0 views2 WordsCopy TextShare
Unknown
Video Transcript:
No transcript available.
Related Videos

25:17
Microbiologia Médica: Actinomyces israelli...
CS Ciências da Saúde
3,844 views

19:16
Microbiologia Médica: Clostridium tetani -...
CS Ciências da Saúde
10,720 views

1:09:59
Aula 25 Listeria moncytogenes
Microbiologia Unirio
613 views

1:18:12
Provas de identificação cocos gram positivos
Professora Nathália Abreu
4,026 views
56:51
PHO Rounds: Listeria in food processing en...
Public Health Ontario
112 views

33:21
Microbiologia Médica: Mycobacterium leprae
CS Ciências da Saúde
9,228 views

47:37
Microbiologia Médica: Corynebacterium diph...
CS Ciências da Saúde
6,563 views
18:17
Detection of Listeria monocytogenes & List...
MicroChem's Experiments
17,134 views

25:36
Microbiologia Médica: Clostridium botulinu...
CS Ciências da Saúde
10,356 views

6:04
Por que Listeria monocytogenes é uma das b...
Clarissa Barretta | Microbiologia de Alimentos
1,571 views

48:58
Microbiologia Médica: Classificação dos Me...
CS Ciências da Saúde
22,500 views

29:27
072. Listeriose - Uma doença de transmissã...
Dra. Deriane Gomes
2,207 views

56:48
Aula Neisseria meningitidis e Haemophilus ...
Fernanda Cavalcante
4,111 views

12:56
Taxonomy of Bacteria: Identification and C...
Professor Dave Explains
365,252 views

35:52
Microbiologia Médica: Shigella
CS Ciências da Saúde
10,005 views

1:06:40
Micro Vet 2016.1 Aula #01 - Staphylococcus...
Prof. Danilo Stipp
25,691 views

23:58
Microbiologia Médica: Bacillus anthracis -...
CS Ciências da Saúde
10,120 views

49:57
Microbiologia Médica: Mycobacterium tuberc...
CS Ciências da Saúde
18,273 views

12:05
Microbiologia Médica: Bacillus cereus - Ba...
CS Ciências da Saúde
15,222 views

40:32
Microbiologia Médica: Principais Meios de ...
CS Ciências da Saúde
26,570 views